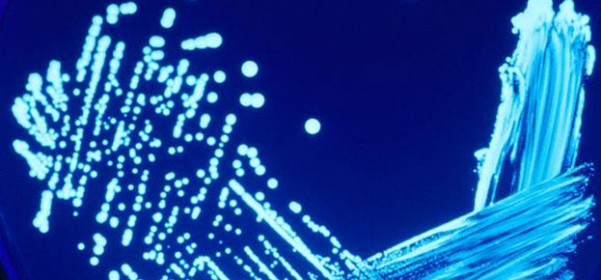
Nuevo alcance de ENAC

Nuevo alcance de ENAC
En días pasados hemos renovado y ampliado nuestro alcance de la Acreditación de ENAC, teniendo ahora acreditados la Detección y Recuento de Legionella spp según la UNE-EN ISO 11731:2007 en aguas de consumo y aguas continentales tratadas no destinadas al consumo humano, el recuento de enterococos en aguas de consumo y aguas de piscinas y la ampliación de parámetros microbiológicos a diferentes matrices.
El alcance de la acreditación de ENAC incluye las matrices de aguas de consumo, aguas residuales, aguas de piscinas, aguas continentales y suelos.
El alcance se puede consultar en el apartado de acreditaciones de nuestra web.
Nuestro trabajo se centra principalmente en los análisis de aguas, en los que somos especialistas, intentando ofrecer soluciones de calidad e ir ampliando nuestro alcance de ENAC para beneficio de nuestros clientes.
Ser especialistas en aguas hace que hagamos muchas veces lo mismo, consiguiendo optimizar costes para nosotros y para nuestros clientes, además de convertirnos en grandes profesionales de lo que hacemos, con las garantías que eso conlleva para un trabajo tan importante como es la salud o el medioambiente.
Alberto Moro
Estudié en la Universidad de Valladolid y soy químico y enólogo por vocación. Posteriormente me especialicé en ingeniería medioambiental en la EOI y en Viticultura y Enología en la Universidad Politécnica de Madrid y ahora dirijo AQM Laboratorios.